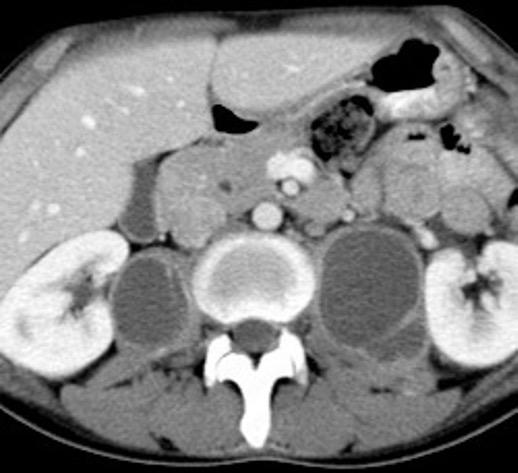

TÓRAX. SIGNOS Y PATRONES RADIOLÓGICOS.
PARTE II. MEDIASTINO.













2. ÍNDICE
3. MEDIASTINO. DEFINICIÓN
4. ANATOMÍA. ÁREAS DEL MEDIASTINO
5. ANATOMÍA. DIVISIÓN EN ÁREAS
6. ÁREAS DEL MEDIASTINO EN TC
7. LÍNEAS,√BANDAS Y ESPACIOS. PROYECCIÓN PA
9. LÍNEAS, BANDAS Y ESPQCIOS. PROYECCIÓN LATERAL
11. SIGNOS DIRECTOS DE LESIÓN MEDIASTÍNICA
13. ÁREAS CIEGAS. PROYECCIÓN LATERAL
69. DESVIACIÓN TRAQUEAL A LA IZQUIERDA
71. DESVIACIÓN TRAQUEAL A LA DERECHA
73. DESVIACIÓN TRAQUEAL POSTERIOR
74. DILATACIÓN ESOFÁGICA: ACALASIA
75. DILATACIÓN MARCADA DE LA TRÁQUEA: SÍNDROME DE MOUNIER-KUHN
77. DISCO INTERVERTEBRAL. CALCIFICACIÓN
78. DOUGHNUT, SIGNO DEL
79. LESIÓN ESTERNAL

81. ESTRECHAMIENTO ASIMÉTRICO DE LA TRÁQUEA
82. ESTRECHAMIENTO CONCÉNTRICO TRAQUEAL
84. ENSANCHAMIENTO MEDIASTÍNICO CON GRASA

127. MASAS DEL ÁNGULO CARDIOFRÉNICO DERECHO.
128. HERNIA DE MORGAGNI
129. MEDIASTINITIS AGUDA
130. MEDIASTINITIS FIBROSANTE

*En el modo “Presentación” se puede acceder a cada signo con un click sobre el nombre de la lista . *Algunos signos tienen más de una diapositiva. Retorno al índice * Esquina superior derecha de la diapositiva.
16. FRECUENCIA DE LESIONES. COMPARATIVA NIÑOS-ADULTOS
17. AREA 1. MEDIASTINO SUPERIOR
19. ÁREA RETROESTERNAL
20. ÁREA CARDIACA
21. ÁREA INFRA-AÓRTICA
22. ÁREA RETROCARDIACA
85. ENSANCHAMIENTO MEDIASTÍNICO AGUDO
87. ENSANCHAMIENTO MEDIASTÍNICO DIFUSO
88. ESPACIO RETROCRURAL. ANATOMÍA
89. ESPACIO RETROCRURAL. GANGLIOS
90. ESPACIO RETROTRAQUEAL DE RAIDER
91. FALSO ENSANCHAMIENTO MEDIASTÍNICO

23. ÁREA PARAVERTEBRAL
25. AORTA ENVUELTA, SIGNO DE LA
26. AORTA “ESTRECHA” SIGNO DE LA
27. BANDA AORTOPULMONAR. DESPLAZAMIENTO
29. BANDA PARA-AÓRTICA. OBLITERACIÓN
31. BANDA PARAESOFÁGICA. DESPLAZAMIENTO
32 . BANDA PARATRAQUEAL DERECHA
34. BANDA PARATRAQUEAL IZQUIERDA
35. BANDA RETROESTERNAL AUMENTADA
37.BANDA TRAQUEOESOFÁGICA ENSANCHADA
38 .BOTÓN AÓRTICO. DOBLE CONTORNO DEL
40. BRONQUIO LSD. ANATOMÍA
41. BRONQUIO LSD. PATOLOGÍA
42. BRONQUIO LSI. ANATOMÍA
43. BRONQUIO LSI. PATOLOGÍA
44. BRONQUIO INTERMEDIARIO. SIGNO DEL
46. CALCIFICACIONES EN CÁSCARA DE HUEVO
48. CAÑONES SUPERPUESTOS, SIGNO DE LOS
49. CERVICOTORÁCICO, SIGNO
53. BPI .COMPRESIÓN Y DESPLAZAMIENTO HACIA ARRIBA DEL
55. BPI . COMPRESIÓN Y DESPLAZAMIENTO HACIA ABAJO DEL
57 ARTERIA SUBCLAVIA IZQUIERDA. CONVEXIDAD DE LA
59. CUERPO VERTEBRAL. AFECTACIÓN CON MASA
60. DENSIDAD ÓSEA. PERDIDA DE
62. LÍNEAS PARAESPINALES. DESPLAZAMIENTO BILATERAL DE
64. LÍNEA PARAESPINAL. DESPLAZAMIENTO UNILATERAL DE
67. DESVIACIÓN TRAQUEAL ANTERIOR
92. FIBROSO. TUMOR MEDIASTÍNICO
93. FORAMEN INTERVERTEBRAL AUMENTADO
95. GANGLIOS CON CALCIO/HUESO
97. GANGLIOS CON CENTRO HIPODENSO
99.GANGLIOS CON HIPERCAPTACIÓN TRAS
CONTRASTE
100 . GRASA SEPARADA, SIGNO DE LA 101.GOOD. SÍNDROME DE
102. HEMATOMA MEDIASTÍNICO.
104. HEMATOPOYESIS EXTRAMEDULAR
106. HIPERPLASIA DEL TIMO “VERDADERA”
107. HIPERPLASIA DEL TIMO DE “REBOTE”
108. LÍNEA DE UNIÓN ANTERIOR
109. LIPOMA INTRACAVA
110. LIPOMA INTRABRONQUIAL
111. LIPOMATOSIS MEDIASTÍNICA
112. MACH. BANDAS DE
113. MASA MEDIASTÍNICA FOCAL
115. MASA MEDIASTÍNICA CON AIRE
117. MASA MEDIASTÍNICA DE DENSIDAD AGUA
118. MASA MEDIASTÍNICA CON CALCIO
119. MASA MEDIASTÍNICA DE DENSIDAD GRASA
120. MASA MEDIASTÍNICA DE DENSIDAD INTERMEDIA
121. MASA MEDIASTÍNICA QUE SE REALZA CON EL CONTRASTE
123 .MASA MEDIASTÍNICA CON ALTA DENSIDAD I INTRÍNSECA
124. MASA INTRATRAQUEAL

131. ESPACIO SUBCARINAL. OCUPACIÓN
133. NEUMOMEDIASTINO
136. PERLAS NEGRAS, SIGNO DE LAS
137. RECESO PLEURO-ÁCIGO-ESOFÁGICO
138. SEUDOTUMORES MEDIASTÍNICOS. 1 DIFUSOS
139. SEUDOTUMORES MEDIASTÍNICOS.
2. MED. SUPERIOR
140. MEUDOTUMORES MEDIASTÍNICOS.
3. MED. ANTERIOR
141. SEUDOTUMORES MEDIASTÍNICOS.
4. MED. PREVERTEBRAL
142. SEUDOTUMORES MEDIASTÍNICOS.
5. MED. PARAVERTEBRAL
143. TERCER MOGUL, SIGNO DEL
145. TIMO EN EL ADULTO
146. TIMOLIPOMA
147. TORACO-ABDOMINAL, SIGNO
149. TORACOABDOMINAL: GANGLIOS
150. TORACOABDOMINAL: S SEUDOQUISTE PANCREÁTICO
151. TRAQUEOPATÍA OSTEOPLÁSTiCA
152. SIGNO DEL 1-2-3
153. VENA CAVA SUPERIOR. SÍNDROME DE 155. VCS SÍNDROME. . TROMBOSIS
156. VENTANA AORTOPULMONAR
159. VERTEBRA PLANA
160. ZENKER. DIVERTÍCULO DE



Mediastino: Del griego: “que está en medio”
Rashidfarokhi M. Ectopic Anterior Mediastinal Pathology in the Chest: Radiologic-pathologic Correlation of Unexpected


Encounters with the “Terrible Ts” . J Clin Imaging 2016

El espacio extrapleural que existe entre ambos conjuntos pleuropulmonares

Contiene:
Tráquea y bronquios principales
Corazón/ Grandes vasos
Timo Conducto torácico
Esófago Ganglios Grasa Nervios






Medio: Saco pericárdico
Superior: Superior al receso pericárdico superior

Anterior: Anterior al saco pericárdico
Posterior: Posterior al pericardio posterior
Interpretación libre del autor. Basado en Gray´s Anatomy. Bartebly. 1918 Receso pericárdico superior




C. Pedrosa








Carter BW et al. A modern definition of mediastinal compartments.
J Thorac Oncol 2014.
Carter BW et al. ITMIG Classification of Mediastinal Compartments and Multidisciplinary Approach to Mediastinal Masses. Radiographics 2017.




























Línea paratraqueal derecha

Línea paratraqueal izquierda





Espacio subcarinal


Línea para-aórtica




Líneas paraespinales



Banda traqueal posterior



Banda retroesternal






Triángulo de Raider

Marano M et al. Cardiac Silhouette Findings and Mediastinal Lines and . Chest 2011.
Pedrosa C y Cabeza B. El Mediastino en Pedrosa C. Diagnóstico por la Imagen. Mc Graw-Hill. Interamericana.1997




Bronquio intermediario























2. Línea PARAespinal
”Lesión ocupante de espacio: 1. Que hace prominencia sobre un borde mediastínico 2. O produce alteración de líneas, bandas o espacios
3. O es visible en lateral. 4. O cualquier combinación de las anteriores.
1. Masas en los bordes


3. Visible en lateral 4.Tráquea desplazada



Linfoma linfoblástico T.



1-2% de los linfomas no-Hodgkin. Muy agresivo.
Chiba Y et al.
Mediastinal T-cell Lymphoblastic lymphoma… Intern Med 2020








1. Aclara zonas anatómicas “ciegas” para la PA.
Detrás o delante de la silueta cardiaca












b. Detrás del esternón












1. Aclara zonas anatómicas “ciegas” para la PA.





d. Columna vertebral



Mastectomía izquierda. Colapsos vertebrales lateral

Niños

15,8 5,1 1,5 0,7


Tumores neurogénicos
Tumores mesenquimales
Enfermedades linfáticas
Tumores germinales
Quistes
Lesiones tímicas
Les. inflamatorias/fibrosis
Metástasis



Tumores neurogénicos
Tumores mesenquimales
Enfermedades linfáticas

Tumores germinales
Quistes
Lesiones tímicas
Enf. inflamatoria/fibrosis
Lesiones tiroideas

Liu T et al. Mediastinal lesions across the age spectrum: a clinicopathological comparison between pediatric and adult patients. Oncotarget. 2017 .





Límite superior: Opérculo torácico
Límite inferior: Borde superior del arco aórtico

1ª costilla



Los límites de la abertura torácica superior coinciden en la PA con el borde interno de la 1ª costilla.
Chiles C et al. Navigating the thoracic inlet. Radiographics. 1999

Anomalías vasculares
Patología tiroidea
Ganglios
Tumores traqueales
Tumores esofágicos

Tumores del sulcus
Tumores de la vaina del nervio
Tumores vertebrales
Infeciones (cuello)
Linfangiomas
Lesiones de la grasa.
Arco aórtico derecho. Bocio intratorácico que desciende por la izquierda




¡Posición de los brazos influye en la imagen!





Pollard DB et al. Preoperative Imaging of Thyroid Goiter: How Imaging Technique Can Influence Anatomic Appearance and Create a Potential for Inaccurate Interpretation. AJNR 2017

Hanneman K et al. Congenital Variants and Anomalies of the Aortic Arch. Radiographics 2017
Aneurisma aórtico
Bocio intratorácico
Ca. de tiroides
Linfoma (LH)
Tumor germinal
Tumor tímico

Hiperplasia tímica
Tumor esternal
Causas de afectación

Linfangioma
Ganglios RETROESTERNAL
Quiste tímico
Quiste broncogénico (raro)
Whitten. Radiographics.2007



Aneurisma aórtico








Timo: Timoma, Carcinoma
Causas de afectación



CARDIACO



T. germinales Aneurisma. (Valsalva, VI.)
Quiste pericárdico, del Vent. derecho Hernia de Morgagni
Grasa del ángulo Tumor cardiaco Ganglios diafragmáticos

Quiste timico, Timolipoma Timoma

Whitten Radiographics. 2007




Causas de afectación
Webb R. 2005

Infraaórtica
FRECUENTES Ganglios. (más frecuente)
Sarcoidosis
Linfoma

Metástasis Ca. de pulmón

Aneurisma aórtico Disección aórtica con aneurisma
Masa mediastínica









Causas de afectación


Dr. C. Pedrosa
Hernia Hiatal/ Paraesofágica
Aneurisma ventricular
Aorta Aneurisma/ Elongación

Esófago
Tumor/Divertículo/
Varices, Ganglios (Lig. Pulmonar y PARA esofágicos)
Bronquios LID y LII
Dilatación de venas pulmonares





Leiomiomas múltiples en esófago, estómago, recto, clítoris.



Fasih N, et al. Leiomyomas beyond the uterus: unusual locations, rare manifestations. Radiographics 2008 RETROCARDIACA
Gibbs JM et al. Radiographics 2007. Marano R et al. Chest 2011








“Quísticas”
Q. hidatídico
Seudoquiste. pancreático
Tumores mesenquimales
Hemangioma
Linfangioma
Meningocele
Absceso vertebral (Tb, Nocardia, Brucella, Estafilo.
Sólidas

T. Neurogénico Schwanoma, Neurofibroma
Ganglioneuroma
Paraganglioma
Tumor vertebral
Quiste óseo aneurismático
Displasia fibrosa
Hematopoyesis extramedular

Linfoma
Metástasis/Mieloma
Familia Ewing (Askin, etc.)
Teratoma (raro)

Panda A et al. “Straddling Across Boundaries”. Thoracoabdominal Lesions: Spectrum and Pattern Approach. Curr Probl Diagn Radiol, 2015


Tórax 70%. Cuello 15%.





Abdomen y pelvis 15%.
En el tórax puede ocupar cualquier área mediastínica.
Puede afectar al pulmón.
Culver GJ et al. Benign Lymphoid Hyperplasia (Castleman's Tumor) Mimicking a Posterior Mediastinal ~Neurogenic tumor. Chest 1997








“Draped aorta”.



Indica rotura aórtica reciente. Se manifiesta por una pared aórtica posterior o el contacto con el borde lateral vertebral borrados por la hemorragia.
A. Yudin, Metaphorical





Rotura aneurisma de Aorta descendente.
Dolor. (10 días antes: "Rotura inminente”)




(“Skinny aorta”)




Aortitis extensa
Enf. de Takayasu.
(Mujeres, 2ª y 3ª décadas)






Coartación aórtica
Pseudocoartación
Vasculitis de grandes vasos
Rotura aórtica

Compresión extrínseca
Radioterapia
Neurofibromatosis
Basado en Kicska G. Narrowed aorta. Stern-Gurney. Expertdd.Chest. Marisys. 2011
Khan R et al. Takayasu’s Arteritis in a 33-Year-Old Male. Cureus 2021

Dr. César Pedrosa
Rotura traumática aórtica.Hematoma toracoabdominal



Grasa, Adenopatías
(Mets, Tb, Ca de pulmón)
Tumor mediastínico
Descrita por Keats representa la interfase de la pleura medial del pulmón izquierdo con el arco aórtico y la arteria pulmonar



Lipomatosis





Keats TE. The aortic-pulmonary mediastinal stripe. AJR. 1972
Gibbs JM et al. Lines and Stripes:Where Did They Go?—From ConventionalRadiography to
















Keats TE. The aortic-pulmonary mediastinal stripe. AJR.1972 Gibbs JM et al. Lines and Stripes:Where Did They Go?—From ConventionalRadiography to CT. Radiographics 2007

Visible en el adulto normal por interfase de la pared externa de la aorta con el aire del LII.



Causas de alteración


Normal
Patología aórtica Disección/ Aneurisma Úlcera ateroesclerótica
Adenopatías/ Ca. de Pulmón Hematoma Patología del LII
Marano R et al .Cardiac Silhouette Findings and Mediastinal Lines and Stripes. Chest 2011




30 años

Borramiento de la banda PARA-aórtica por AdenoCa. de LII, no visible en 2005









Colapso de LII. TC: secreciones bronquiales.
Endoscopia tapón mucopurulento extraído








Borramiento parcial por Ca. epidermoide.

“BANDA
Visualización (95% de normales) de la pared derecha del esófago hasta su entrada en el cardias.



Tumores esofágicos
Dilatación esofágica (Acalasia, etc.).
Adenopatías









Interfase de la pleura del LSD con la pared traqueal


Máx. Grosor 4 mm.
Presente en 83-97% de normales
Marano R et al. Chest. 2011




Aumento del grosor



Normal Pared traqueal (tumor, inflamación) Engrosamiento pleural Ganglios Infiltración mediastínica (hemorragia, tumor, infección).


Sarcoidosis.


La densidad aumentada con desplazamiento lateral de la VCS es el signo más fiable

Adenopatías > 15 mm. (98 pacientes)
Ensanchamiento de la banda paratraqueal........35%
Aumento del ganglio de la ácigos.......................42%
Convexidad lateral de la VCS.................................47%
Densidad aumentada en la zona de la VCS.........83%
Müller NL. et al. Radiology 1985






Ca epidermoide cavitado





Visible en21-31% de normales
Woodring..Med Radiogr Photogr 1986


No visible debido Art. Subclavia izda./ Art. Carótida izda. Gibbs. Radiographics. 2007








Normal: 2-4,5 mm.
La suma de 2 bandas paraesternales y 1 retroesternal









Contiene: Grasa extrapleural
Vasos mamarios internos Ganglios Nervios intercostales
Lesión esternal Adenopatías (MI) Circulación colateral (coartación) Post-esternotomía media. Webb. 2005 Coartación aórtica



Ca. de mama . (219 pacientes)
Ganglios + = 45. (20. 5%)

Diámetro medio:1. 95 cm
Ocupación de espacios intercostales : 1.............43% 2.............26% 3.............22% 4...............9%
Unilateral........32
Bilateral..........13
Scatarige. Radiology 1988
















Ca. esofágico
Lesión traqueal
Art. subclavia aberrante
Ca de pulmón. Webb. WR. 2005










Hodgkin clásico de esclerosis nodular.











Adenopatías región cervical y mamaria interna, prevasculares y VAP. Doble contorno aórtico.



1. Anomalías vasculares
V. Cava izda. etc.

2.Disección, aneurisma aórtica
3. Ganglios







4. Desplazamiento de la banda aorto -pulmonar. (Grasa, Adenopatías (Mets, Tb, Ca de pulmón) Hematoma intramural aórtico que sube a los troncos. Drenaje anómalo de VPSI a Vena innominada.

Lateral: Visible 50% de normales








Más grande y más borroso
Proto AV,. The left lateral radiograph of the chest. Part One. Med. Radiogr. Photogr.1979.

Patología
¡Visualización buena!

Sospecha de ganglios aumentados, en el hilio derecho . Proto AV.1979
Sarcoidosis










Whitten CR. A Diagnostic Approach to Mediastinal Abnormalities. Radiographics 2007 / Marano R et al. Cardiac Silhouette findings And mediastinal lines and stripes. Chest. 2011

Anatomía
BPI: 75% de normales




La imagen es probable que represente al BPI, a la altura del nacimiento del BLSI.






AV,. The left lateral radiograph of the chest. Part One. Med. Radiogr. Photogr.1979.










La presencia de tumor o ganglios rodeando el BPI hace que este aparezca como mucho más nítido y definido.
Carcinoma microcítico..
Parálisis frénica. Atelectasia parcial de LSI.



Whitten CR. A Diagnostic Approach to Mediastinal Abnormalities. Radiographics 2007 / Marano R et al. Cardiac Silhouette findings And mediastinal lines and stripes. Chest. 2011

En el normal, el bronquio intermediario (BI) aparece en la proyección lateral, como una línea fina vertical que cruza el bronquio del LSI en su unión con el principal. (BPI) Engrosamiento del bronquio intermediario (BI)


97% de normales





Causas
Fallo cardiaco
Ca de pulmón
Metástasis
Linfoma
Sarcoidosis
Castleman


Schnur MJ et al.. Thickening of the Posterior Wall of the Bronchus Intermedius. Radiology. 1981

Fallo cardiaco











MJ et al.. Thickening of the Posterior Wall of the Bronchus Intermedius. Radiology. 1981 Ca. microcítico

Neumoconiosis


Gross GH et al. Egg-Shell calcification of lymph nodes. An update. AJR 1980
Silicosis (5%)
Neumoconiosis del carbón (1,3-6%)

Sarcoidosis. ( 5%)
Hongos y bacterias. Tuberculosis. Cocidioidomicosis
Histoplasmosis
Amiloidosis Idiopática

Silicosis




Grayson CE et al. Egg Shell calcification in silicosis. Radiology 1949












Silicosis secundaria al pulido con chorro de arena. Tejidos ”Denim”. (vaqueros, etc.)


Marchiori E et al. Conglomerated masses of silicosis in sandblasters: High-resolution CT findings. Eur Radiol 2006
Alper F,, et al. CT findings in silicosis due to denim sandblasting. Eur Radiol. 2008

“ESCOPETA DE
(No lo busquen en Internet me lo acabo de inventar)

En el normal solo es visible nítido, el círculo del BPI. Cuando ambos, BPI y el bronquio del LSD, son claramente visibles, hay que sospechar adenopatías hiliares bilaterales
















Si una masa sobrepasa la clavícula, es posterior. (No hay mediastino anterior por encima del manubrio y de la clavícula)


Felson B. More chest roentgen signs and how to teach them. Annual Oration in memory of L. Henry Garland, Radiology.1968





La lateral confirma la posición posterior del tumor que sobrepasa la línea del manubrio








Felson B. More chest roentgen signs and how to teach them. Annual Oration in memory of L. Henry Garland, Radiology.1968

Si el borde de una masa se interrumpe al llegar a la clavícula debe ser anterior. No existe mediastino anterior por encima de la clavícula, solo cuello.

Felson B. More chest roentgen signs and how to teach them. Annual Oration in memory of L. Henry Garland, Radiology.1968













Felson B. More chest roentgen signs and how to teach them. Annual Oration in memory of L. Henry Garland, Radiology.1968


Bocio




> Aurícula izquierda (Aurícula gigante)
Lesión mitral
Estenosis aórtica

Ganglios subcarinales
Linfoma
Ca de pulmón metastático
Sarcoidosis
Tuberculosis Quiste broncogénico Derrame pericárdico Tumor esofágico




Rao S. et al. A Significant Pericardial Effusion Leading to Bronchial Compression: A Case Report . Journal of Investigative Medicine High Impact Case Reports. 2021
Muller NL et al. Subcarinal Lymph Node Enlargement: Radiographic Findings and CT Correlation . AJR 1985
Rusinaru D et al. Left Atrial Volume and Mortality in Patients With Aortic Stenosis. J Am Heart Assoc. 2017

> Aurícula izquierda.
(Aurícula gigante)
Lesión mitral
Estenosis aórtica









Diámetro borde cardiaco derechopared inferior del bronquio principal izquierdo debe ser en el normal < 7cm




Higgins CB et al. Left atrial dimension on the frontal thoracic radiograph: a method for assessing left atrial enlargement. AJR 1978



Aneurisma aórtico
Ganglios paratraqueales
izquierdos + VAP



Sarcoidosis, Metástasis, Tb, etc.
Paraganglioma
Aneurisma de arteria bronquial
Compresión por art. pulmonares.
Hipertensión pulmonar
Ausencia de válvula pulmonar
Anillos vasculares
Broncomalacia Post-Tb
Masas mediastínicas. (Bocio, etc.)



Aneurisma aórtico
Duke RA et al. Compression of Left Main Bronchus and Left Pulmonary Artery by Thoracic Aortic Aneurysm . AJR 1987
Wilson SR et al. CT Visualization of Mediastinal Bronchial Artery Aneurysm. AJR 2006
Zhong M-Y et al. Multi-slice computed tomography assessment of bronchial compression with absent pulmonary valve. Pedriat Radiol 2014


Ganglios. Tumor pélvico: Sarcoma de células redondas tipo Ewing












Causas de afectación




La línea de la arteria subclavia izquierda (ASI) es cóncava en el normal

ASI NORMAL

Frecuentes
Elongación de troncos
Aneurismas de ASI/ACI
Anomalías vasculares
Bocio/ Ca. de tiroides
Ganglios/ Grasa
Menos frecuentes
Tumores traqueales
Masas esofágicas
Tumor neurogénico
Tumores de Pancoast






Aneurisma de ASI
Aneurismas de TSA
74 pacientes
Degenerativos…63%
Iatrogénicos……24%

Trauma…………..8%
Genético………..3%
Micótico…………1%
ASD…50%. 2/3 lado dcho.
Carótida común 36%%
Carótida interna ..10%
TBD…………………..3%
Vertebral……………1%









Cury M et al.Supra-aortic vessels aneurysms: diagnosis andprompt intervention. J Vasc Surg. 2009


Mal de Pott
Mieloma
Metástasis
Hemangiomas

Hematopoyesis extramedular
Enf. de Castleman
Linfoma
Tumor neurogénico
Meningocele

Hemangiomas







Invasión frecuente de estructuras vecinas ( p.ej. lesión neurológica) Extensión torácica concomitante ……….2% Múltiples áreas de afectación….………...2% Flebolitos……………10%



Osteoporosis
Menopausia
Esteroides
Infiltración neoplásica
Mieloma múltiple
Metástasis








1. Osteoporosis en Alzheimer con desnutrición, hipoproteinemia y déficit de B12.















Neoplasia primitiva
Metástasis
Mieloma múltiple
Ganglios. (LLC, linfoma)
Osteofitos/ Lipomatosis
Fibrosis
Espondilodiscitis
Tb, Brucella, Cocos,

Inespecífica
Hematoma mediastínico
Hematopoyesis
extramedular
Meningoceles
Sistema ácigos dilatado
Tumor neurogénico
Fracturas vertebrales




Lipomatosis.



32% asociadas a Enf. autoinmunes o fibroinflamatorias.

Vasculitis ANCA
Vasculitis de grandes vasos
Fibrosis retroperitoneal










Rossi GM et al. Idiopathic Mediastinal Fibrosis: a Systemic Immune-Mediated Disorder. A Case Series and a Review of the Literature. Clin Rev Allergy Immunol. 2017

Tumores neurogénicos
Masa paravertebral. ( Castleman, Metástasis, Paraganglioma, Linfoma)
Meningocele, Lipoma, Lipomatosis,



Neoplasia vertebral Hemorragia o Hematoma (Trauma, Discrasia)
Espondilitis ( TB, Malta, Estafilo.)
Enf. Aórtica (Aneurisma, laceración)
Derrame pleural ¡libre en Dec. Supino!





Schwanoma









Grandes: Realce heterogéneo. Áreas de baja atenuación por grasa o degeneración quística
10% calcificación. A veces periférica. (schwanoma “viejo”)
Pvlus JD et al. Imaging of Thoracic Neurogenic Tumors. AJR 2016


Causas malignas
Ganglios: Linfoma, Leucemia
N. Malignas: Metástasis, Mieloma.

Invasión directa:
Ca. de pulmón




Carcinoma microcítico


Tumor primario óseo Sarcoma granulocítico (Cloroma), Sarcoma osteogénico, Angiosarcoma, etc.



Bollen L et al. Prognostic factors associated with survival in patients with symptomatic spinal bone metastases: a retrospective cohort study of 1043 patients. Neuro-Oncology. 2017



Anillo vascular:
Arco aórtico derecho/doble
ASD anómala, etc.

Maldonado JA et al. Congenital
Thoracic Vascular Anomalies.
Radiol Clin N Amer. 2010


¡Siempre que veas desviación anterior de la tráquea, piensa primero en anomalía vascular!
Pulmonary sling.
Aneurisma aórtico
Bocio Quiste broncogénico
Tumor traqueal / esofágico
Dilatación esofágica
Hematoma Metástasis
Arco aórtico derecho












Berniker AV et al. Intimal Problems: A Pictorial Review of Nontraumatic Aortic Disease at Multidetector tor Computed Tomography. Current Problems in Diagnostic Radiology 2018.








Bocio/Ca. tiroides Ganglios. (Ca. de pulmón, Linfoma Tb, Sarcoide)
T. Mediastínicos
Aumento TSA
Elongación/Aneurisma





Arco aórtico dcho. aneurismático
Aneurisma de Art. subclavia aberrante
Shahrzad M et al. Anterior Mediastinal Masses. AJR. 2014



2. Causas:

Atelectasia izquierda.
Resección pulmonar
Fibrotórax
Hipoplasia pulmonar izda. Pérdida de volumen del hemitórax/ pulmón izquierdo.




Pulmón destruens
Woodring JH et al. Types and mechanisms of pulmonary atelectasis. J Thorac Imaging. 1996
Dr. C Pedrosa







Aneurisma aorta
Elongación
Seudoaneurisma


Ganglios VAP. T. mediastínicos
Ca. de pulmón Bocio (raro)
Neumotórax a tensión
Derrame pleural masivo
Masas pleurales/pared
Hemorragia/hematoma mediastínico
Elefteriades JA et al. Thoracic aortic aneurysm clinically pertinent controversies and uncertainties . J Am Coll Cardiol . 2010
C








2. Pérdida de volumen del hemitórax derecho Fibrotórax calcificado con cavidad residual

Atelectasia del LSD. Resección pulmonar Fibrotórax
Pulmón destruens
Hipoplasia pulmonar dcha.
Bronquiectasias diseminadas
Conglomerado silicótico








Kim HS et al. Thoracic Sequelae and Complications of Tuberculosis. Radiographics 2001


Aneurisma AA Ateroesclerosis
Lúes

Shahrzad M et al. Anterior Mediastinal Masses. AJR. 2014
Seudoaneurisma Disección aórtica
Hematoma
post-cirugía
Bocio Absceso Hematoma
Teratoma
Timoma
Ganglios










“Banda
PARA-esofágica
Visualización 95%



1. Tumores esofágicos
2. Dilatación esofágica (Acalasia, etc.).
3. Adenopatías Borde












Mounier-Kuhn
Fibrosis del lóbulo superior (Tb, Sarcoidosis) Neumonitis de hipersensibilidad Espondilitis anquilopoyéytica Ehlers-Danlos

Traqueobroncomegalia de Mounier-Kuhn con neumonía del LID
Wegner F. CT of Mounier -Kuhn Disease. Radiology 2020



Traqueobroncomegalia de Mounier-Kuhn
Dilatación marcada de tráquea y grandes bronquios.


Traqueobroncomalacia 67% + Protrusión del tejido músculo-membranoso redundante entre los anillos cartilaginosos.(diverticulosis traqueal)
Infección respiratoria recurrente (88%)
Debilidad del aparato muco -ciliar Fumadores.




Schmitt P et al. Respiratory Conditions Associated with Tracheobronchomegaly (Mounier-Kuhn Syndrome): A Study of Seventeen Cases. Respiration 2016

Wegner F. CT of Mounier-Kuhn Disease. Radiology 2020


Amiloidosis
Degenerativa
Infección/Trauma
Fusión vertebral


Espondilitis anquilopoyética
Ocronosis
Hiperparatiroidismo
Gota, Condrocalcinosis
Hemocromatosis
Enf. deposición de apatita

Calero I et al. Carta al Editor. Reumato. Clin. 2015

Ganau A. Cap 76. Columna vertebral. en Pedrosa C. Diagnóstico por Imagen. Interamericana. 2004
Anillo radiopaco formado por ganglios aumentados. El centro radiotransparente lo constituyen tráquea y bronquios centrales. Más frecuente en Tb y linfoma







Chiarenza et al. Chest imaging using signs, symbols, and naturalistic images: a practical guide for radiologists and non-radiologists. Insights into Imaging. 2019.





Trauma
Luxación y fractura

Artritis
Séptica
Reumática
Artrosis





Metástasis: Tiroides, Mama, Tiroides, Riñón, Pulmón, Linfoma
Primario maligno: Condrosarcoma, Mieloma, Linfoma, Osteosarcoma
Primario benigno (raro)

Metástasis de Hepatocarcinoma 1-20% de metástasis óseas.









Tráquea en sable



Estrechamiento en plano coronal con diámetro normal en el sagital
60 pacientes con EPOC.
97% tráquea en sable.






Greene R et al: “Saber-sheath” trachea: a clinical and functional study of marked coronal narrowing of the intrathoracic trachea. Radiology 1975
También en asociación con
Lipomatosis mediastínica.
lHoskins MC. Clinical Radiol 1991





Traqueobroncomalacia
Bocio intratorácico
Carcinoma tiroides



Lipomatosis / Amiloidosis
Traqueobroncopatía osteoplástica
Policondritis recidivante
Papilomatosis laríngea
Wegener
Neoplasia traqueal
Rinoescleroma

Policondritis recidivante

Basado en: Gurney JW. Large airways. en Expert ddx. Chest. Amirsys. 2011













Enfermedad autoinmune. Condritis auricular 95%.
Afectación ocular. 50-67%. Monoartritis/Poliartritis. 52-85%.
Afectación laringotraqueal..67%. (esp. subglótica)

Shrof GS et al. Pathology of the Trachea and Central Bronchi. Semin Ultrasound. CT MRI 2016


1. Lipomatosis difusa
S. de Cowden
Proteus/Cloves
Enf. de Dercum
En. de Madelung
Inducida por drogas
Lipomatosis difusa




Esteroides/Retrovirales
Familiar difusa
Landis MS et al. Radiology 2009











Hematoma intramural
Disección aórtica
Rotura de aneurisma aórtico

Mediastinitis aguda
Absceso mediastínico




TRAUMA
Rotura esternal
Hematoma mediastínico
Rotura aórtica
Fractura vertebral



Rotura esofágica Perforación esofágica
Mod. de Brandt 2007


Se atragantó con una tostada


Estreptoquinasa en coronariografía
Anticoagulación mal controlada.

(incluye hemopatía)
Resucitación “vigorosa”
Postcirugía
Hematoma infectado
Seudoaneurisma
Rotura de conducto linfático
Catéter(V. Subclavia, etc.)
Biopsia
Mod. de Brandt 2007








Hematoma retroesternal y pericárdico en cirugía de válvula mitral. Migración de suturas

Boiselle P.M.et al. Wandering wires: frequency of sternal wire abnormalities in patients with sternal dehiscence. AJR 1999;







“De abertura torácica a diafragma”.









Contiene: Grasa. Aorta y ramas
Venas ácigos y hemiácigos
Troncos simpáticos y nervios esplácnicos





Aneurisma aórtico
Ganglios, conducto torácico y cisterna chili.
Plexo venoso lumbar
Restrepo CS et al.. The diaphragmatic crura and retrocrural space: normal imaging appearance, variants, and pathologic conditions . Radiographics. 2008





Adenopatías del espacio retrocrural

1. Inflamatorias (Sarcoidosis, etc.)
2. Infecciones (TB, MAI, SIDA)
3. Linfoma/leucemia


4.Metástasis/Neuroblastoma/ T. Testiculares/Ca. GI (esófago, estómago) Ca. Genitourinario






Restrepo et al. Radiographics. 2008 Leucemia linfática crónica


Arco aórtico doble, ASD aberrante con arco aórtico izquierdo y derecho.
Aneurisma (aórtico, AS aberrante)




Normal
Divertículo de Zenker, Acalasia, Q. duplicación, Bocio, T. neurogénico, Hemangioma, Linfangioma, Hematoma Tuberculosis, Absceso





Raider L. The Retrotracheal Triangle. Chest. 1973./ Franquet T et al.
The Retrotracheal Space: Normal Anatomic and Pathologic Appearances. RadioGraphics. 2002






Atelectasias de lóbulos superiores por Radioterapia + lipomatosis en Ca. de pulmón radiado



Enfermedad pulmonar bilateral adosada.
Atelectasia “tumoral”
Empiema pleural mediastínico
Anomalía vascular






Tumores pluripotenciales con componentes fibroblásticos o miofibroblásticos. Hemangiopericitoma es parte de estos tumores.

Histologicamente hay variantes “sin patrón”, otros “hemangiopericitomalike”, angiofibroma-like, fibrosarcoma-like o esclerosante difuso.




Chick. JFB Solitary Fibrous Tumors..AJR 2013





Neurofibroma
Ausencia congénita/ hipoplasia de pedículo

Ectasia dural (Marfan Ehlers-Danlos)
Neoplasia intraespinal Destrucción metastática
Dahnert. 2017





Tsirikos AI et al. Assessment of vertebral scalloping in neurofibromatosis type 1 with plain radiography and MRI . Clin Radiol . 2004








Tsirikos AI et al. Assessment of vertebral scalloping in neurofibromatosis type 1 with plain radiography and MRI . Clin Radiol . 2004








Preda L et al. Calcified metastatic mediastinal lymph nodes from mucinous breast adenocarcinoma.
Eur Radiol 2004/ Patel SV, et al. CT demonstration of calcified metastatic mediastinal lymph nodes. Clin Radiol 1998

Tb/ Hongos


Sarcoidosis
Silicosis Ca. de pulmón



Linfoma (post tto.)







Pneumocistis
Amiloidosis
Castleman











Metástasis: Osteosarcoma Tiroides Colon Ovario


Carcinoma mucinoso. (mama, ovario, etc.)

AdenoCa. de pulmón






0,84% en no tratados. Apter. S. AJR.2002. Ganglios tratados

En ganglios tratados



2-8% > 8 meses después.
McLennan TW et al... Radiology 1975
Bertrand M, et al. AJR 1977
Strijk SP. Acta Radiol Diagn. 1985
Linfoma de Hodgkin irradiado años antes







Tuberculosis
Metástasis de Ca. epidermoide de pulmón, ovario, seminoma, tiroides, estómago

Linfoma Tratado/Hodgkin no tratado.(21%)
Micobacteria no Tb
Sarcoidosis (raro)




Tb ganglionar
Hiperplasia nodal grasa/Whipple
Leucemia/Adenitis viral (herpes simple)
Mod. de Brant WE et al. Fundamentals of Diagnostic Radiology.2007
Hopper KD et-al. AJR 1990/ Webb WR. The Mediastinum en Thoracic Imaging.2005











31 años.. VIH+ C-3. Inmunosupresión severa. Tb miliar,ganglionar y pulmonar
Hopper KD et-al. AJR 1990/ Webb WR. The Mediastinum en Thoracic Imaging.2005





Sarcoma de Kaposi
Castleman
Linfoadenopatía
angioinmunoblástica
Metástasis de:
Ca. Papilar de tiroides. Hipernefroma. Estómago



Ca. microcítico de pulmón
Melanoma



Ca. gástrico
Cabral FC et al. Hypervascular mediastinal masses: Action points for radiologists. Eur J Radiol 2015




“Split fat sign”






Abreu E et al. Peripheral tumor and tumor-like neurogenic lesions. Eur J Radiol 2013 Área de densidad grasa visible en la periferia de tumores neurogénicos , especialmente en schwanomas “viejos” y en tumores de nervios largos. Se puede apreciar mejor en estudios de RM. (Anillo hiperintenso en T1.)




Timoma con hipogammaglobulinemia
Infecciones de todo tipo.(Incluido Covid-19) Aplasia de hematíes
Liquen plano.

Diarrea crónica
Síndrome mielodisplásico Pancitopenia. Miastenia gravis






Paganelli R et al. Insights from a Case of Good’s Syndrome (Immunodeficiency with Thymoma. Biomedicines 2023/Lindahl H et al. COVID-19 in a patient with Good’s síndrome and in13 patients with common variable immunodeficiency. Clinical Immunology Communications. 2021.















b. Iatrogénico
Postcirugía
Hematoma infectado





Seudoaneurisma
Rotura de conducto
linfático
Catéter (V. Subclavia, etc.)
Biopsia

Punción de vena subclavia.
Paciente con religión alternativa y con Púrpura trombocitopénica.





Fenómeno compensatorio por función insuficiente de médula ósea.


Mielofibrosis. Policitemia vera. Leucemia Linfoma.

Post-irradiación de médula ósea. Anemias hemolíticas. esp. Talasemia intermedia/ minor)





Haidar R. Paraspinal extramedullary hematopoiesis in patients with thalasemia intermedia. Eur Spine 2010



Lesiones inactivas “viejas”: alta intensidad de señal en T1 y T2. (infiltración grasa) Depósito de hierro: Baja intensidad de señal en T1 y T2





RM: Hipo intensidad de señal. Hemosiderosis secundaria. ¡Hígado! Haidar R. Paraspinal extramedullary hematopoiesis in patients with thalasemia intermedia. Eur Spine 2010








1. Hiperplasia folicular linfoide. Asociada a miastenia gravis, Enf. del tejido conectivo. Hipoplasia de células rojas, Infección en HIV+
Jóvenes normales



Nasseri F et al. Clinical and Radiologic Review of the Normal and Abnormal Thymus: Pearls and Pitfalls. Radiographics 2010 Miastenia. Hiperplasia folicular linfoide tímica



2. Hiperplasia de rebote.


Aumento de tamaño con tejido normal. Asociada a hipertiroidismo, sarcoidosis, aplasia de células rojas.
Más frecuente después de quimioterapia, quemaduras, stress







Masa intrabronquial de la pirámide del LII. Tumor carcinoide típico. Hiperplasia tímica
Nasseri F et al. Clinical and Radiologic Review of the Normal and Abnormal Thymus: Pearls and Pitfalls. Radiographics 2010



Contacto entre los pulmones y la grasa retroesternal.
La V separa ambos pulmones de parte del corazón y de la grasa mediastínica.



Visible : 24,5%-57% de las PA







Kattan KR et al. Superior Mediastinal Shift in Right Lower Lobe Collapse. Radiology 1975/ Marano R et al. Cardiac Silhouette Findings and Mediastinal Lines and Stripes. Radiograph and CT Scan Correlation. Chest 2011

Paciente con fibrosis mediastínica por silicosis y síndrome

Thorogood SV. Brit J Radiol 1996
Vinnicombe S. JCAT 1994.
DD: Trombo Tumor 1º y 2º





Wahad A et al. Lipoma of superior vena cava: a rare ocurrence. BMJ Case Rep 2017



















Pavlov PV et al. Endobronchial lipoma: a rare cause of subsegmental bronchial obstruction. Respirol Case Rep. 2020







SC et al.. Fat containing lesions of the chest. Radiographics. 2002






Fenómeno óptico de realce de bordes y tiene que ver con un fenómeno de inhibición lateral en la retina.


Ha sido estudiado con fotómetros que miden la intensidad del gradiente en las áreas señaladas y no existe gradiente alguno de densidad.
Dificultad para ver en planos, convexo y cóncavo.
Chasen MH. Band Theory in thoracic analysis. Radiology. 2001







a. De borde bien definido. la pleura es el límite)

b. La cúpula apunta hacia el pulmón
c. Ángulos obtusos
d. Signo de la silueta con estructura en contacto




Felson B. Localization of intrathoracic lesions. In: Chest roentgenology. Phila-delphia, PA: Saunders, 1973.
¡El vestido de embarazo! Felson. B




Signo definitivo de la situación extrapleural:
de:





Felson B. Localization of intrathoracic lesions. In: Chest roentgenology. Phila-delphia, PA: Saunders, 1973.


Frecuentes
1. Hernia del hiato
2. Divertículo de Zenker
3. D. esofágico

Menos frecuentes
1. Acalasia
2. Perforación esofágica
3. Absceso mediastínico
4. Post-cirugía Raras
1. Quiste broncogénico









2. Neumomediastino tabicado
3. Divertículo traqueal
Divertículo gigante de esófago
Stern. Gurney .Expert ddx. Chest. Amirsys. 2011






VCSI: Vena cava superior izquierda.
TVBI: Tronco venoso braquiocefálico izquierdo







Operada de lesión aórtica. Aneurisma de TBD. Dehiscencia de suturas. Alambre de pared a espacio mediastínico anterior. Gas en Med. Ant. Ausencia de VCS. VCS izquierda a seno coronario dcho.
Basado en: Franquet T. Air-containing Mediastinal Mass. Large airways. en Expert ddx. Chest. Amirsys. 2011



Timoma quístico
Linfangioma
Quistes. (18-25% de todas las masas)
Tímico
Pericárdico/Esofágico
Hidatídico

Meningocele lateral
Teratoma
Hematoma/Seroma /Absceso/Secuestro
Seudoquiste pancreático
Ascitis en hernia hiatal

Quiste celómico alto Vargas D et al. Cystic lesions of the mediastinum. Semin Ultrasound CT MRI. 2016










Bocio endotorácico
T. neurogénicos
Hemangioma ( flebolitos)
Lipoma
Teratoma
Timoma
T. germinales








2º tumor neurogénico en frecuencia
25-43% de los casos.
Calcificación.… 25%. Finas
Shin JH et al. Neuronal tumors of the central nervous system: radiologic findings and pathologic correlation. RadioGraphics 2002 Ganglioneuroma


Masas

Hiperplasia tímica
Lipoma/ Lipoma VCS

Teratoma Calcificación 20-43%.
Grasa. Dientes




Liposarcoma mediastínico Hernias diafragmáticas. (Hiatal Paraesofágica. Morgagni. Bochdalek)
Quiste/Seudoquiste linfático
Hematopoyesis extramedular Teratoma/ Linfangioma

Scott. SC.. Radiographics. 2002. Naidich DP et al. Computed Tomography.2007. Kazerooni EA et al. The Cardio. Pulmonary Imaging.2004


Drevelegas A et al. Mediastinal germ cell tumors: a radiologic - pathologic review. Eur Radiol 2001

Los trombos arteriales presentan densidad intermedia, entre la densidad grasa y la densidad “agua”










Aneurisma aórtico con área de trombosis




Menos frecuentes:
Varices
Mediastinitis aguda
Enf. de Castleman
Sarcoma de Kaposi
Hemangioma
Frecuentes:
Aneurisma
Bocio







Metástasis/Paraganglioma
Hematopoyesis extramedular
Basado en: Gurney JW. Contrast-enhancing Mass..en Sten. Gurney. Expertdd/Chest.Amirsys.2011



Aneurisma aórtico de localización poco habitual
Edad: 40-50 años
3% segregan catecolaminas.

(En el área Paravertebral +/-50%.)
Intenso realce con el contraste.








32 años .Preeclampsia a los 19. Hipertensión no controlada. Masa paravertebral sólida que se realza intensamente con afectación ósea.

Yue Y t al. Asymptomatic left posterior mediastinal functional Paraganglioma. A case report. Medicine . 2019


Tiroides normal/ Bocio
Ca. de tiroides

Hemorragia mediastínica
Hematoma intramural aórtico
Quiste broncogénico (a veces)
Post- linfografía







Hematoma mediastínico post-cirugía aórtica con alta densidad y derrames pleurales (densidad baja)
Mod. de Glazer HS et al. High-attenuation mediastinal masses on unenhanced CT. Radiology 1991



1. No tumorales.

Moco
Traqueobroncopatía osteocondroplástica
Amiloidosis
Cuerpo extraño


Aneurisma VI calcificado. post infarto. Varios ictus Broncoaspiración. Tapón de moco en tráquea, carina y bronquios principales.
Calcificaciones bronquiales extensas.




Hong SR et al. Differentiation Between Mucus Secretion and Endoluminal Tumors in the Airway:




Carcinoma quístico adenoideo




Tumores malignos
Ca. epidermoide (más frecuente) Adenocarcinoma.
Carcinoide
Ca. neuroendocrino
Ca. Microcítico

El tumor más frecuente de origen salival. 4ª y 5ª décadas.


Ca. adenoideo quístico (2º en frecuencia) Bedayat A et al. Tracheobronchial Tumors: Radiologic Pathologic Correlation of Tumors and Mimics. Current Problems in Diagnostic Radiology. 2019

Frecuente: Invasión local y Recurrencias locales.

Park CM et al. Tumors in the Tracheobronchial Tree: CT and FDG PET Features. Radiographics. 2009


Secundario


a. Invasión directa Tiroides, pulmón, laringe, esófago
b. Metástasis Melanoma, Mama, Riñón, Colon






Benignos Papiloma Papilomatosis Hamartoma, Lipoma Leiomioma,
Azhar W et al. Whistling Lipoma: Bronchial Obstruction Caused by a Lipoma. Cureus 2020/
Park CM et al. Tumors in the Tracheobronchial Tree: CT and FDG PET Features. Radiographics. 2009



Grasa del ángulo Hernia de Morgagni



T. Mediastínicos
Q. Pericárdico /AD Necrosis grasa
> Aurícula derecha Divertículos
Q. pericárdico > Raíz aórtica. Aneurisma del Seno de Valsalva












Defecto anteromedial (Espacio de Larrey) Desarrollo anómalo del septum trasversum. 2-3% de las hernias.
> En lado derecho. Mujeres, edad media, obesidad

Vasos omentales



Molinari F et al. Fat-Containing Lesions in Adult Thoracic Imaging. AJR. 2011./ Gossios KJ et al. Omental herniation through the foramen of Morgagni. Diagnosis with chest computed tomography . Chest 1991.

Infección de cuello Pastene B et al. Mediastinitis in the intensive care unit patient: a narrative review. Clin Microbiol infect.2020












Adultos jóvenes Síndrome de VCS, Compresión de tráquea, etc.

Idiopática. Se asocia a tiroiditis de Riedel, Fibrosis retroperitoneal. AR y enf. autoinmune.
Metisergida Localizada 82%.
Lentamente progresiva












Normal

Espacio normal
Densidad baja uniforme del espacio. Pared interna de BPI-BI visible.

BPI sin alteraciones Ángulo carinal normal




Crecimiento AI
Ganglios Quiste broncogénico

Ganglios subcarinalesl Ángulo carinal normal

Sarcoidosis
Müller NL et al. Subbcarinal Lymph Node Enlargement: Radiographic Findings and CT Correlation. AJR 1985











Criado E et al. Pulmonary sarcoidosis: typical and atypical manifestations at highresolution CT with pathologic correlation. Radiographics. 2010



Trauma torácico
Rotura alveolar
Asma



Ventilación mecánica
Submarinismo
Fumar mariguana
Fumar cocaína
Espontáneo
OTROS Alteración retroperitoneal
Rotura de víscera hueca
Cirugía retroperitoneal torácica
Trauma/fractura facial
Extracción dental



Signo del diafragma continuo

Zylak. CM. Pneumomediastinum revisited. RadioGraphics 2000. de Lacey et al. The chest X-ray. A survival guide. Saunders. 2013

Enfisema subcutáneo


Aire paratraqueal

Silueta cardiaca





Zylak. CM. Pneumomediastinum revisited. RadioGraphics 2000.


Med. anterior .
Anillo periarterial






Retrocardiaco





Zylak. CM. Pneumomediastinum revisited. RadioGraphics 2000.















Ramana. RV et al. The “Cluster of black pearls” sign of sarcoid lymphadenopathy: a new sign on thin-section contrast-enhanced multidetector CT. Clinical Radiology 2017
2-3 cm por debajo del espacio subcarinal












Linfoma de Hodgkin escleroso-nodular





Mediastinitis fibrosa. Fibrosis retroperitoneal.






10-20% de los casos de FM difusa
Reacción a Enf. Autoinmunes. (LED, AR)
Hematopoyesis extramedular
Metersigida / Radioterapia. Enf. inmunoglobulina IgG4. (Riedel, Colangitis, etc.)



2. Mediastino superior
a. Congénitas
Aneurisma sobre arteria aberrante
Anomalía venosa


Retorno venoso anómalo
VCS izquierda persistente
Circulación colateral (coartación)
b. Divertículo traqueal








Paciente con linfoma B de base de cráneo
Aneurisma del tronco costo-cervical
Punciones de: Vena subclavia.
Vena yugular interna
Mazzei V, cervical trunk pseudoaneurysm following central venous catheterization.J Card Surg. 2011.Lang EV et al. Delayed rupture of a pseudoaneurysm of the costocervical trunk: Radiology 1991

2. Mediastino anterior
Vasculares

a. Aneurisma aórtico



Ateroesclerótico/ Luético
b. Aneurisma del seno de Valsalva de la raíz aórtica
c. Aneurisma de art. coronaria
No vasculares
a. Hernia de Morgagni
b. Lipomatosis del ángulo
c. Divertículo de aurícula derecha








Efteriades, JA et al. Thoracic Aortic Aneurysm Clinically Pertinent Controversies and Uncertainties.
3. Mediastino prevertebral
a. Causas arteriales

1. Arco aórtico derecho/doble
2. Aneurisma aórtico
Ateroesclerótico/ Micótico/Aortitis







3.. Seudoaneurisma aórtico
4. Disección aórtica
b. Causas no aórticas
1. Dilat./aneurisma de Art. pulmonar
2. Dilat./aneurisma V. ácigos
3. Seudoquiste linfático
4. Crecimiento de aurícula izquierda








3. Mediastino paravertebral
1. Región paraespinal
a. Lipomatosis paraespinal
b. Absceso paravertebral
c. Hematopoyesis extramedular
d. Hernia de Bochdalek

e. Aneurisma/Seudoaneurisma aórtico







“TERCER

Joroba en el contorno cardiaco, en el tercer segmento Quiste pericárdico



FRECUENTES: Aneurisma del VI. > Orejuela Tumor mediastínico ( Timoma, etc.)
POCO FRECUENTES: Tumor cardiaco/ o pericárdico Ausencia de pericardio Quiste pericárdico o hidatídico
Miocardiopatía
Post-cirugía
Enf. Congénita cardiaca




Restrepo CS et al.. Primary pericardial tumors. Radiographics 2013.













Restrepo CS et al.. Primary pericardial tumors. Radiographics 2013.
TIMO EN EL
(Restos tímicos)

Tamaño mayor del timo: Entre los 12 y 19 años. Mayor tamaño en RM de Geer G. Radiology 1986


Visualización TC de 154 pacientes < de 30 años…100% 30-49 años…….73% > 49años………..17%
Baron. Radiology 1982

Regresión del parénquima y remplazamiento graso: desde los 20 hasta los 60 años. (la mitad del peso para entonces)
Nishino M et al. The Thymus: A Comprehensive Review. Radiographics. 2006






CORTESÍA: Dr. Orueta

Raro. (2-9% de los T. tímicos). Asintomático. Contiene grasa (hasta 90%) y tejido timico (10-33%). Pueden ser muy grandes y confundirse con cardiomegalia. La tomografía “clásica” muestra los límites de la silueta cardiaca. (flechas)






Líneas paraespinales formando un “paréntesis” por encima del diafragma. El signo señala el origen “intratorácico” de la lesión.
Conrad A et al. Pott’s disease associated with large and multiple abscesses in a 30-year-old migrant from Chad. BMJ Case Rep 2018





(lesiones toracoabdominales) La divergencia de las líneas paraespinales apunta a lesión toracoabdominal, que desde el tórax desciende y penetra en el abdomen.




Signo del “iceberg” positivo en Tb vertebral

Afectación por vía hematógena. Región dorsolumbar más frecuente. Afectación inicial: irregularidad de los platillos vertebrales, disminución del disco intervertebral con esclerosis ósea adyacente. Kim. Radiographics.2001
Felson B. More chest roentgen signs and how to teach them. Annual Oration in Memory of L Henry Garland. MD. 1903-1966. Radiology 1968

T. mixto de células


Ganglios retroperitoneales (flechas negras)





germinales del testículo izquierdo Nódulos pulmonares múltiples. (flechas verdes). Ganglios paratraqueales. (flechas amarillas). Dudoso ensanchamiento retrocrural (flechas negras)





Panda A et al. “Straddling Across Boundaries”. Thoracoabdominal Lesions: Spectrum and Pattern Approach. Curr Probl Diagn Radiol, 2015
“Seudoquiste pancreático”
5. Otras lesiones
Neoplasias
T. Cél. Gangliónicas
Metástasis (Seminoma)





Linfoma
Hematop. extramedular
Seudoquiste pancreático
Espondilitis infecciosas
3 rasgos:

1. Conexión entre mediastino y lesión pancreática.
2. Derrame pleural

Matsusue E et al.Three cases of mediastinal pancreatic pseudocysts. Acta Radiol Open. 2016 .
3. Hallazgos de pancreatitis. Panda A et al. “Straddling Across Boundaries”. Thoracoabdominal Lesions: Spectrum and Pattern Approach.Curr Probl Diagn Radiol, 2015






1/300 autopsias. Broncoscopia ..0,7%.
5ª-6ª décadas. + Varones.













2/3 inferiores de tráquea y bronquios principales. Sólo pared anterior y laterales. + Asintomáticos

Prince JS et-al. Nonneoplastic lesions of the tracheobronchial wall: radiologic findings with bronchoscopic correlation. Radiographics. 2002/ Shrof GS et al. Pathology of the Trachea and Central Bronchi. Semin Ultrasound CT MRI 2016


Triada de Garland




Ganglios paratraqueales derechos e hiliares bilaterales


95% de pacientes tienen ganglios hiliares bilaterales aislados o con afectación mediastínica (espec. paratraqueal derecho).
Criado E et al. Pulmonary sarcoidosis: typical and atypical manifestations at high-resolution CT with pathologic correlation. Radiographics. 2010



Síntomas y signos que se producen con la obstrucción total o parcial de la vena cava superior

Causas Malignas +/- 90-95%
Ca. Broncogénico (80-85%)
Linfoma No Hodgkin (15%)
Catéteres, shunts y marcapasos…23%
T. Mediastínico. Bocio
Fibrosis Idiopática
Tb, Histoplasmosis, Actinomicosis, Sarcoidosis





Carcinoma microcítico con síndrome de VCS


Grupos:

1. Obstrucción por encima de la V Ácigos. (La sangre llega al corazón a través de ella)




2. Obstrucción con participación de la V. Ácigos. (La sangre utiliza otras alternativas para llegar al corazón vía VCI).






Participación de la V. Ácigos como vía principal para llegar a la VCI.


















Visible: 88%
Depresión ligera…….55% profunda. 35%












FRECUENTES Ganglios. (más frecuente)
Webb R. 2005 Aneurisma aórtico Disección aórtica con aneurisma Masa mediastínica (incl. Ca. de pulmón)








Boiselle PM et-al. Imaging of mediastinal lymph nodes: CT, MR, and FDG PET. Radiographics. 1998

Ganglios frecuentes
Sarcoidosis


Ca. de pulmón
Metástasis
Esófago Mama
Tiroides Mesotelioma
T. Tímico

Sarcoidosis






Kligerman S Abbott G.A Radiologic Review of the New TNM Classification for Lung Cancer. AJR.2010
Boiselle PM et-al. Imaging of mediastinal lymph nodes: CT, MR, and FDG PET. Radiographics. 1998

Histiocitosis
Fractura (trauma)
Osteogénesis imperfecta.
Granuloma eosinófilo
Tumor hematológico
Mets, mieloma, leucemia.




Sarcoma de Ewing
Infección
Esteroides (necrosis avascular)
Hemangioma
Osteoblastoma

Baky F et al. Vertebra Plana in Children May Result from Etiolo Fgies Other Than Eosinophilic Granuloma. Clin Orthop Relat Res. 2020

Surek J et al. MRI in patients with tuberculous spondylitis presenting as vertebra plana: a retrospective analysis and review of literature . Clin Radiol 2013


Fracturas dorsales


Wu M.-H., Huang T.-J., Cheng C.-C., Li Y.-Y., Hsu R.W.-W. Role of the supine lateral radiograph of the spine in vertebroplasty for osteoporotic vertebral compression fracture: A prospective study. BMC Musculoskelet. Disord. 2010;


a disfunción cricofaríngea y gastroesofágica.
Carlucci LR et al. Radiographics 2015






Halland M et al.Dysphagia in a patient with a Zenker's Diverticulum: there is more than meets the eye.
Gastroenterology 2014



